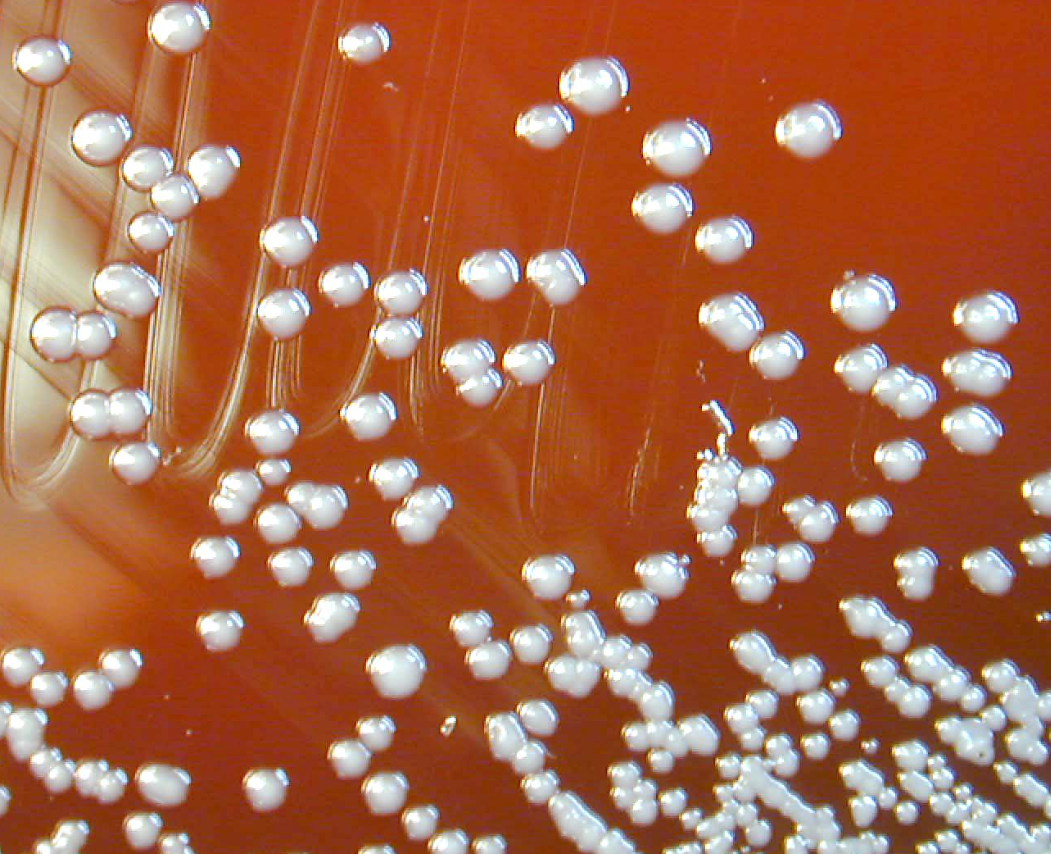

6人死亡!英国四款湿纸巾因细菌感染被撤柜,家里有的赶紧扔!
近日,英国发布紧急健康警告:数款受污染的非无菌湿巾已导致6人死亡,59人感染。英国健康安全局(UKHSA)及药品监管部门(MHRA)呼吁民众立即封存并丢弃相关产品。

由于此类湿巾常用于急救包或家庭药箱,请大家务必自查,防止因误用伤口导致致命后果。
致命细菌导致大量死伤
这次事件的始作俑者,是一种叫做稳定伯克霍尔德菌 (Burkholderia stabilis)的细菌:它天然存在于土壤和水中,具有极强的生命力。
身体健康的普通人感染概率较低,但对于免疫力低下者(如化疗患者、器官移植者、囊性纤维化患者)来说,它极具攻击性。
一般来说,这种细菌能通过破损皮肤、伤口,或经由静脉注射导管等医疗器械进入人体。2018年6月至2026年2月期间,英国共确诊59例相关感染,其中6人不幸去世。

而卫生安全局公布的死伤数据背后,就有至少一例死亡案例与涉事湿纸巾直接关联。
感染症状及风险
一旦通过伤口感染,可能会出现以下症状:
伤口周围出现红肿、发热、剧烈疼痛。
伤口处有流脓或其他异常分泌物。
最坏情况,便是细菌引发败血症(全身炎症反应),直接危及生命。
⚠️ 涉事品牌黑名单
检测显示,以下四款非无菌、不含酒精(Alcohol Free)的湿巾被稳定伯克霍尔德菌”污染。请认准品牌名,切勿继续使用:
ValueAid Alcohol Free Cleansing Wipes

Microsafe Moist Wipe Alcohol Free

Steroplast Sterowipe Alcohol Free Cleansing Wipes

Reliwipe Alcohol Free Cleansing Wipes

虽然这几款产品已于去年7月停售,且官方强调它们并非普通的“婴儿湿巾”或“日常湿巾”,但由于其保质期长,仍可能遗留在很多家庭的急救包中。
💡 专家特别提醒
立即自查: 检查家中医药箱,如发现上述品牌,请直接丢入生活垃圾桶。
分清“无菌”与“非无菌”: 普通非无菌湿巾(如本文提到的品牌)绝对不能用于清理伤口、破损皮肤或医疗插管。
伤口护理原则: 建议使用医用碘伏、酒精棉球或专门的“无菌级”护理产品处理伤口。

